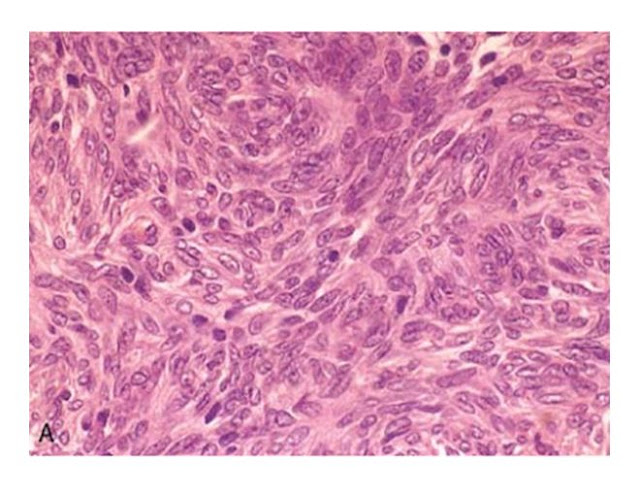

A domain name to help students study and to facilitate learning in whatever ways possible using online hosting, medical ebooks, smartphone apps (apple iphone, google android), college notes etc Like study in abroad so that they not only get academic degree but also life insurance of thorough knowledge so they don't go hiring accident attorneys or go out fashion shopping books. All software material here is collected with sincerity, love and passion. God Bless you all. Donate me in ur prayers!
Don't Know Where to go?? Search Here!!
Pathology Slides Presentation by Sir Asghar Javaid
SPECIAL THANKS to DR. NABEEL AKHTAR (N-57) for contibuting this Presentation.
hold Ctrl then press + to increase or - to decrease the size.
This karyotype of 46, XY, t(8;14)
demonstrates the translocation typical for a Burkitt type (small non-cleaved) lymphoma
Burkitt
lymphoma. A, At low power, numerous pale tingible body macrophages are evident, producing
a "starry sky" appearance.
B, At high power, tumor cells have
multiple
small nucleoli and high mitotic index.
The lack of significant variation in nuclear shape and size lends a monotonous
appearance. (B, courtesy of Dr. José Hernandez, Department of
Pathology, University of Texas
Southwestern Medical School, Dallas, TX.)
Follicular lymphoma (lymph node). A,
Nodular aggregates of lymphoma cells are present throughout lymph node.
B, At high magnification, small lymphoid
cells with
condensed chromatin and irregular or
cleaved nuclear outlines (centrocytes) are mixed with a population of larger
cells with nucleoli (centroblasts). (A, courtesy of Dr. Robert W.
McKenna, Department of Pathology,
University of Texas Southwestern Medical School, Dallas, TX.)
Diffuse large B-cell lymphoma. Tumor
cells have large nuclei, open chromatin, and prominent nucleoli. (Courtesy of
Dr. Robert W. McKenna, Department of Pathology,
University of Texas Southwestern Medical
School, Dallas, TX.)
diagnosis is: malignant lymphoma, small
lymphocytic type, diffuse
This is a malignant lymphoma, small
cleaved cell type, follicular (also known as: malignant lymphoma, poorly
differentiated lymphocytic type, nodular).
The malignant lymphocytes here are very
large with a moderately abundant cytoplasm, and the nuclei are round to ovoid
with prominent nucleoli and occasional mitoses. The diagnosis is diffuse
malignant lymphoma, large cell type (also known as: immunoblastic lymphoma).
The cells are large, with prominent
nucleoli and abundant cytoplasm
large cell lymphomas
Diagnostic Reed-Sternberg cell, with two
nuclear lobes, large inclusion-like nucleoli and abundant cytoplasm, surrounded
by lymphocytes, macrophages, and an eosinophil
B, Reed-Sternberg cell, mononuclear
variant
C,
Reed-Sternberg cell, lacunar variant.
D, Reed-Sternberg cell, lymphohistiocytic (L&H) variant
Hodgkin lymphoma, mixed cellularity type
This is Hodgkin's disease, nodular
sclerosis type. Note the bands of pink collagenous tissue dividing the field.
Hodgkin lymphoma, nodular sclerosis type
nodular sclerosing Hodgkin's disease has prominent bands of
fibrosis
the lacunar cells characteristic for the
nodular sclerosis type of Hodgkin's disease.
Hodgkin lymphoma, lymphocyte predominance
type
large cells with large, pale nuclei
containing large purple nucleoli at the arrowheads. These are Reed-Sternberg
cells
With antibody to CD-15, this immunoperoxidase stain demonstrates the Reed-Sternberg
and lacunar cells characteristic for Hodgkin's disease
CML
CML
Myeloid cells of CML are also
characterized by the Philadelphia chromosome (Ph1) on karyotyping. This is a
translocation of a portion of the q arm of chromosome 22 to the q arm of
chromosome 9, designated t(9:22).
Cml
spleen
A, Nucleated red cell progenitors with multilobated or multiple nuclei
B,
Ringed sideroblasts, erythroid progenitors with iron-laden
mitochondria, seen as blue perinuclear granules (Prussian blue stain)
C, Pseudo-Pelger-Hüet cells, neutrophils with only two nuclear
lobes instead of normal three to four, are observed at the top and bottom of
this field
D, Megakaryocytes with multiple nuclei
instead of the normal single multilobated nucleus. (A, B, D, marrow aspirates; C, peripheral blood smear.)
AML
acute myelogenous leukemia is seen here. There is one lone
megakaryocyte at the right center
Acute promyelocytic leukemia (FAB M3 subtype)
Acute monocytic leukemia (FAB M5b subtype)
CLL
NORMAL BONE MARROW
CLL
Anaplastic large cell lymphoma. A,
Several "hallmark" cells with horseshoe-like or
"embryo-like" nuclei and abundant cytoplasm lie near the center of
the field
. B,
Immunohistochemical stain demonstrating expression of ALK
protein. (Courtesy of Dr. Jeffrey Kutok, Department of Pathology, Brigham and
Women's Hospital, Boston, MA.)
BENIGN THYMOMA
MALIGNANT THYMOMA
Mantle cell lymphoma. A, At low power, neoplastic lymphoid
cells surround a small, atrophic germinal center, exhibiting a mantle zone
pattern of growth.
B, High-power
view shows a homogeneous population of
small lymphoid cells with somewhat irregular nuclear outlines, condensed
chromatin, and scant cytoplasm. Large cells resembling
prolymphocytes (seen in chronic lymphocytic leukemia)
and centroblasts (seen in follicular lymp
Lymphoplasmacytic lymphoma. Bone marrow biopsy shows a
characteristic mixture of small lymphoid cells exhibiting various degrees of
plasma cell differentiation. In
addition, a mast cell with purplish-red
cytoplasmic granules is present at the left-hand side of the field.
BCL2 expression in reactive and
neoplastic follicles. BCL2 protein was detected by using an immunohistochemical technique that produces a brown stain.
In reactive
follicles (A), BCL2 is present in mantle
zone cells but not follicular center B cells, whereas follicular lymphoma cells
(B) exhibit strong BCL2 staining
Subscribe to:
Comments (Atom)